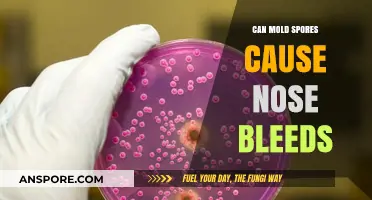
Mold Spores and Nosebleeds: Uncovering the Surprising Connection

Mold spores are microscopic particles released by mold fungi as part of their reproductive process, and they are commonly found both indoors and outdoors. While mold spores themselves are not typically harmful, they can trigger allergic reactions in sensitive individuals, leading to symptoms such as itching. When inhaled or when they come into contact with the skin, mold spores can cause irritation, particularly in people with mold allergies or compromised immune systems. Itching may occur as a result of the body's immune response to these spores, which can manifest as skin rashes, hives, or generalized discomfort. Additionally, prolonged exposure to mold spores in damp environments can exacerbate these symptoms, making it essential to address mold growth and improve indoor air quality to minimize potential health risks.
| Characteristics | Values |
|---|---|
| Can mold spores cause itching? | Yes, mold spores can cause itching in some individuals. |
| Mechanism | Mold spores can trigger allergic reactions, leading to skin irritation and itching. This occurs when the immune system responds to mold allergens, releasing histamines that cause itching. |
| Common Symptoms | Itching, redness, rash, sneezing, runny nose, and watery eyes. |
| Affected Areas | Skin, eyes, nose, throat, and lungs. |
| Risk Factors | Individuals with mold allergies, asthma, or compromised immune systems are more susceptible. |
| Prevention | Reduce mold exposure by controlling indoor humidity, fixing leaks, and using air purifiers. |
| Treatment | Antihistamines, corticosteroids, and avoiding mold exposure can alleviate symptoms. |
| Medical Advice | Consult a healthcare professional for persistent or severe symptoms. |
| Latest Research | Studies continue to explore the link between mold exposure and skin conditions, emphasizing the importance of mold remediation in affected environments. |
Explore related products
What You'll Learn

Mold Allergies and Itching
Mold spores are a common trigger for allergic reactions, and itching is a frequent symptom experienced by those sensitive to these microscopic particles. When mold spores are inhaled or come into contact with the skin, they can provoke an immune response in susceptible individuals, leading to a range of allergic symptoms. This reaction occurs because the immune system mistakenly identifies the mold spores as harmful invaders, releasing chemicals like histamine to combat them. Histamine is a key player in allergic reactions, causing inflammation and itching.
Understanding the Itch: A Sensory Response
The itching associated with mold allergies is a result of the body's complex sensory system. When mold spores land on the skin or are inhaled, they can stimulate nerve endings, triggering a signal to the brain that is interpreted as an itch. This sensation is the body's way of alerting you to potential irritation or harm. For allergy sufferers, this response can be particularly intense, leading to a strong urge to scratch. However, scratching provides only temporary relief and can further irritate the skin, potentially causing more harm than good.
A Comparative Perspective: Mold vs. Other Allergens
Itching caused by mold allergies shares similarities with reactions to other allergens like pollen or pet dander. All these allergens can induce a histamine release, resulting in itching, sneezing, and watery eyes. However, mold spores have unique characteristics. They are lightweight and can remain airborne for extended periods, easily infiltrating indoor spaces. This makes mold a persistent allergen, especially in damp environments. Unlike seasonal allergens, mold can cause year-round symptoms, making it a constant concern for allergy sufferers.
Practical Tips for Relief
Managing mold-induced itching involves a multi-faceted approach. Firstly, identify and address mold sources in your environment. This may include fixing leaks, improving ventilation, and using dehumidifiers to reduce moisture levels. Regular cleaning with mold-inhibiting solutions can also help. For immediate symptom relief, over-the-counter antihistamines can be effective. These medications block histamine receptors, reducing itching and other allergy symptoms. For severe cases, a healthcare professional might prescribe stronger antihistamines or recommend immunotherapy to desensitize the immune system to mold allergens.
A Preventative Approach
Preventing mold growth is key to avoiding allergic reactions. This is especially important for individuals with known mold allergies. Simple measures like promptly fixing water leaks, ensuring proper ventilation in bathrooms and kitchens, and regularly cleaning areas prone to moisture can significantly reduce mold spores. In regions with high humidity, using air conditioners and dehumidifiers can help maintain optimal indoor humidity levels, typically below 50%. By controlling moisture, you can effectively minimize mold growth and, consequently, reduce the likelihood of itching and other allergic symptoms.
Mold Spores and Fatigue: Uncovering the Hidden Health Connection
You may want to see also

Skin Irritation from Spores
Mold spores, though microscopic, can provoke noticeable skin reactions in susceptible individuals. When these airborne particles land on the skin, they may trigger irritation, redness, or itching, particularly in those with pre-existing sensitivities or allergies. This reaction occurs because the immune system misidentifies the spores as harmful invaders, releasing histamines that cause inflammation and discomfort. Unlike direct mold exposure, which often involves visible growth, spore-induced irritation can arise even in environments with hidden or minimal mold presence, making it harder to pinpoint the source.
For those experiencing spore-related skin irritation, identifying and mitigating exposure is crucial. Practical steps include using a HEPA air purifier to reduce airborne spores, especially in damp areas like basements or bathrooms. Wearing long sleeves and gloves when handling mold-prone materials, such as compost or old books, can also minimize skin contact. Over-the-counter antihistamines like cetirizine (10 mg daily for adults) or topical hydrocortisone cream (1% applied twice daily) can alleviate itching and inflammation. However, if symptoms persist or worsen, consulting a dermatologist is essential to rule out underlying conditions like eczema or fungal infections.
Children and the elderly are particularly vulnerable to spore-induced skin irritation due to their more sensitive skin and potentially weaker immune systems. For children, ensure their play areas are mold-free and avoid storing toys in damp environments. Elderly individuals should monitor indoor humidity levels, ideally keeping them below 50%, to discourage spore proliferation. Gentle, fragrance-free moisturizers can help maintain the skin barrier, reducing susceptibility to irritation. Always patch-test new products to avoid additional allergic reactions.
Comparatively, spore-related skin irritation differs from contact dermatitis caused by direct mold exposure. While the latter often results in more severe, localized reactions, spore irritation tends to be milder but more widespread, mimicking conditions like hives. This distinction highlights the importance of addressing both visible mold and invisible spores in environmental management. Regularly inspecting and cleaning areas prone to moisture accumulation, such as window sills and shower tiles, can prevent spore buildup and reduce the risk of irritation for all household members.
Mastering Mushroom Spore Harvesting: A Step-by-Step Guide for Beginners
You may want to see also

Airborne Spores and Reactions
Mold spores are ubiquitous in both indoor and outdoor environments, and their presence in the air we breathe is nearly unavoidable. These microscopic particles, released by fungi as part of their reproductive cycle, can become airborne and travel significant distances. When inhaled, they often go unnoticed by the immune system, but for some individuals, exposure triggers a cascade of reactions. The key question here is whether these airborne spores can directly cause itching, a symptom commonly associated with allergies and skin irritation.
From an analytical perspective, the link between mold spores and itching lies in the body’s immune response. When spores enter the respiratory system, they can provoke an allergic reaction in sensitive individuals. Histamine, released by the immune system to combat perceived threats, is a primary culprit. While histamine is most commonly associated with respiratory symptoms like sneezing or coughing, it can also affect the skin. For instance, airborne spores that settle on the skin or are inhaled and subsequently trigger systemic histamine release may lead to localized itching, particularly in areas like the face, neck, or arms. This reaction is more likely in individuals with pre-existing allergies or compromised skin barriers.
To mitigate the risk of itching caused by airborne mold spores, practical steps can be taken. First, monitor indoor humidity levels, keeping them below 50% to discourage mold growth. Use air purifiers with HEPA filters to reduce spore concentration in enclosed spaces, especially in bedrooms and living areas. For those prone to allergies, wearing a mask during outdoor activities in damp or mold-prone environments can limit inhalation. If itching occurs, over-the-counter antihistamines like cetirizine (10 mg daily for adults) or topical hydrocortisone creams (1% for mild cases) can provide relief. However, persistent symptoms warrant consultation with a healthcare professional to rule out underlying conditions.
Comparatively, while mold spores are a common allergen, their impact on itching is often overshadowed by more immediate symptoms like nasal congestion or eye irritation. Yet, for individuals with atopic dermatitis or eczema, even low levels of airborne spores can exacerbate skin sensitivity. This highlights the importance of a holistic approach to managing indoor air quality. Regularly cleaning air vents, fixing leaks, and using mold-resistant products in bathrooms and kitchens can significantly reduce spore counts. For children and the elderly, who are more susceptible to respiratory and skin reactions, these measures are particularly critical.
In conclusion, while not the most direct symptom of mold spore exposure, itching can indeed be a consequence of airborne spores, especially in vulnerable populations. Understanding the mechanisms behind this reaction empowers individuals to take proactive steps in prevention and treatment. By combining environmental control, personal protective measures, and appropriate symptom management, the discomfort caused by these invisible particles can be minimized, ensuring a healthier living space.
Can Concrobium Effectively Kill C-Diff Spores? A Comprehensive Guide
You may want to see also
Explore related products
$19.99

Mold-Induced Hives Symptoms
Mold spores, when inhaled or come into contact with the skin, can trigger an allergic reaction in sensitive individuals, leading to mold-induced hives. This condition, also known as urticaria, manifests as raised, itchy welts on the skin, often appearing suddenly and disappearing within 24 hours. The itching associated with mold-induced hives can be intense and may interfere with daily activities, sleep, and overall quality of life. According to the American College of Allergy, Asthma, and Immunology (ACAAI), mold allergies affect approximately 10% of the population, with symptoms ranging from mild itching to severe respiratory issues.
Recognizing Mold-Induced Hives
To identify mold-induced hives, look for clusters of red or skin-colored bumps that are warm to the touch and intensely itchy. These hives may appear in various sizes and shapes, often merging into larger patches. They typically occur within minutes to hours of exposure to mold spores, which can be found indoors in damp areas like basements, bathrooms, and kitchens, or outdoors in decaying leaves and compost piles. A key indicator is the temporal relationship between mold exposure and the onset of symptoms. For instance, if hives develop shortly after cleaning a moldy area or spending time in a damp environment, mold-induced hives are a likely culprit.
Managing and Preventing Mold-Induced Hives
Effective management of mold-induced hives involves both symptom relief and environmental control. Over-the-counter antihistamines such as cetirizine (10 mg daily) or loratadine (10 mg daily) can alleviate itching and reduce the severity of hives. For severe cases, a healthcare provider may prescribe oral corticosteroids or epinephrine for anaphylactic reactions, though these are rare. Prevention is equally crucial. Maintain indoor humidity below 50% using dehumidifiers, promptly fix leaks, and regularly clean areas prone to mold growth with a solution of bleach and water (1 cup bleach per gallon of water). Wearing gloves and a mask during mold cleanup can minimize direct exposure to spores.
Comparative Analysis: Mold-Induced Hives vs. Other Allergic Reactions
While mold-induced hives share similarities with hives caused by other allergens like pollen or pet dander, the persistence and location of symptoms can differ. Mold-related hives often recur in environments with high mold concentrations, whereas seasonal allergens cause hives during specific times of the year. Additionally, mold exposure can lead to chronic symptoms if the source is not eliminated, unlike acute reactions to food allergens. Understanding these distinctions helps in tailoring treatment and prevention strategies. For example, while avoiding pollen may involve staying indoors during high-count days, preventing mold-induced hives requires ongoing environmental vigilance.
Practical Tips for Immediate Relief
For immediate relief from mold-induced hives, apply a cold compress to the affected area to reduce itching and swelling. Calamine lotion or over-the-counter hydrocortisone cream (1% strength) can also provide temporary relief. Avoid scratching, as it can break the skin and lead to infection. If hives persist for more than a few days or are accompanied by difficulty breathing, dizziness, or swelling of the face and throat, seek medical attention promptly. These could be signs of a severe allergic reaction requiring immediate intervention. By combining symptom management with proactive environmental control, individuals can effectively mitigate the impact of mold-induced hives on their health and well-being.
Are Magic Mushroom Spores Legal in the US? Exploring the Law
You may want to see also

Preventing Itch from Mold Exposure
Mold spores are a common trigger for allergic reactions, and itching is a frequent symptom of mold exposure. When mold spores land on the skin or are inhaled, they can provoke an immune response, leading to inflammation and irritation. This reaction is often immediate but can also develop over time with repeated exposure. Understanding how to prevent this itch is crucial for anyone living or working in environments prone to mold growth.
One of the most effective ways to prevent itching from mold exposure is to control indoor humidity levels. Mold thrives in damp conditions, typically in areas with humidity above 60%. Investing in a dehumidifier can significantly reduce moisture in the air, making it harder for mold to grow. Regularly check humidity levels with a hygrometer, aiming to keep them between 30% and 50%. Additionally, fix any leaks in plumbing, roofs, or windows promptly, as standing water and dampness are breeding grounds for mold.
Personal protective measures are equally important when dealing with mold. If you suspect mold in your home or workplace, wear long sleeves, gloves, and a mask to minimize skin and respiratory exposure. HEPA masks, in particular, can filter out mold spores, reducing the risk of inhalation. After potential exposure, shower immediately and wash clothes separately to avoid cross-contamination. For those with known mold allergies, over-the-counter antihistamines like cetirizine (10 mg daily) or loratadine (10 mg daily) can help manage itching and other allergic symptoms.
For long-term prevention, consider professional mold remediation if the infestation is severe. DIY removal can sometimes worsen exposure, spreading spores into the air. Certified professionals use specialized equipment to contain and eliminate mold safely. Afterward, improve ventilation by using exhaust fans in bathrooms and kitchens, and ensure air conditioning systems are regularly cleaned and maintained. Natural mold inhibitors, such as tea tree oil diluted in water (2 teaspoons per cup), can also be sprayed on surfaces prone to mold growth as a preventive measure.
Finally, monitor your environment for early signs of mold, such as musty odors or visible growth on walls, ceilings, or fabrics. Regularly inspect areas like basements, attics, and under sinks, where mold often hides. For individuals with persistent itching or other severe symptoms, consult an allergist or dermatologist for personalized treatment options, which may include prescription medications or immunotherapy. By combining environmental control, protective measures, and proactive monitoring, you can effectively prevent itching caused by mold exposure.
Equinox's Abilities: Can They Proc Saryn's Spores in Warframe?
You may want to see also
Frequently asked questions
Yes, mold spores can cause itching in some individuals, particularly those with mold allergies or sensitivities. When mold spores come into contact with the skin, they can trigger an allergic reaction, leading to symptoms like itching, redness, or rashes.
Mold spores are airborne and can be inhaled or come into contact with the eyes. In sensitive individuals, they can irritate the nasal passages or eyes, causing itching, sneezing, or watery eyes as part of an allergic reaction.
Yes, airborne mold spores can cause itching even without direct contact. Inhaling mold spores can trigger systemic allergic reactions, leading to symptoms like itching skin, nasal itching, or throat irritation, especially in those with mold sensitivities.